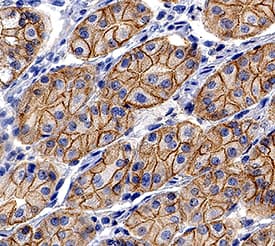

Human/Mouse E-Cadherin Antibody
R&D Systems, part of Bio-Techne | Catalog # AF648


Key Product Details
Validated by
Species Reactivity
Validated:
Cited:
Applications
Validated:
Cited:
Label
Antibody Source
Product Specifications
Immunogen
Asp155-Ile707
Accession # P12830
Specificity
Clonality
Host
Isotype
Scientific Data Images for Human/Mouse E-Cadherin Antibody
Detection of Human and Mouse E‑Cadherin by Western Blot.
Western blot shows lysates of A431 human epithelial carcinoma cell line, A549 human lung carcinoma cell line, HepG2 human hepatocellular carcinoma cell line, P19 mouse embryonal carcinoma cell line, and 4T1 mouse breast cancer cell line. PVDF membrane was probed with 0.5 µg/mL of Goat Anti-Human/Mouse E-Cadherin Antigen Affinity-purified Polyclonal Antibody (Catalog # AF648) followed by HRP-conjugated Anti-Goat IgG Secondary Antibody (Catalog # HAF017). A specific band was detected for E-Cadherin at approximately 110 kDa (as indicated). This experiment was conducted under reducing conditions and using Immunoblot Buffer Group 1.Detection of Human E-Cadherin by Simple WesternTM.
Simple Western lane view shows lysates of Exosome Standards (HT-29) (NBP3-11685) and A431 human epithelial carcinoma cell line, loaded at 0.5 mg/ml. A specific band was detected for E-Cadherin at approximately 123 kDa (as indicated) using 5 µg/ml of Goat Anti-Human/Mouse E-Cadherin Antigen Affinity-purified Polyclonal Antibody (Catalog # AF648) followed by HRP-conjugated Donkey Anti-Goat Secondary Antibody (Catalog # 042-206). This experiment was conducted under reducing conditions and using the 12-230kDa separation system.Detection of E‑Cadherin in MCF‑7 Human Cell Line by Flow Cytometry.
MCF-7 human breast cancer cell line was stained with Goat Anti-Human/Mouse E-Cadherin Antigen Affinity-purified Polyclonal Antibody (Catalog # AF648, filled histogram) or isotype control antibody (Catalog # AB-108-C, open histogram), followed by Allophycocyanin-conjugated Anti-Goat IgG Secondary Antibody (Catalog # F0108). View our protocol for Staining Membrane-associated Proteins.Applications for Human/Mouse E-Cadherin Antibody
CyTOF-ready
Dual RNAscope ISH-IHC Compatible
Sample: Immersion fixed paraffin-embedded sections of human stomach
Flow Cytometry
Sample: MCF‑7 human breast cancer cell line
Immunocytochemistry
Sample: Immersion fixed BG01V human embryonic stem cells, immersion fixed human epidermoid carcinoma cells, and immersion fixed A549 human lung carcinoma cell line untreated or treated with 10 ng/ML TGF-beta (Catalog # 240-B) for 48 hours
Immunohistochemistry
Sample: Immersion fixed paraffin-embedded sections of human stomach
Simple Western
Sample: Exosome Standards (HT-29) (Catalog # NBP3-11685), 4T1 mouse breast cancer cell line, P19 mouse embryonal carcinoma cell line, A431 human epithelial carcinoma cell line, and MCF‑7 human breast cancer cell line
Western Blot
Sample: A431 human epithelial carcinoma cell line, A549 human lung carcinoma cell line, HepG2 human hepatocellular carcinoma cell line, P19 mouse embryonal carcinoma cell line, and 4T1 mouse breast cancer cell line
Reviewed Applications
Read 6 reviews rated 4 using AF648 in the following applications:
Formulation, Preparation, and Storage
Purification
Reconstitution
Formulation
*Small pack size (-SP) is supplied either lyophilized or as a 0.2 µm filtered solution in PBS.
Shipping
Stability & Storage
- 12 months from date of receipt, -20 to -70 °C as supplied.
- 1 month, 2 to 8 °C under sterile conditions after reconstitution.
- 6 months, -20 to -70 °C under sterile conditions after reconstitution.
Background: E-Cadherin
Epithelial (E)‑Cadherin (ECAD), also known as cell-CAM120/80 in the human, uvomorulin in the mouse, Arc-1 in the dog, and L-CAM in the chicken, is a member of the Cadherin family of cell adhesion molecules. Cadherins are calcium-dependent transmembrane proteins which bind to one another in a homophilic manner. On their cytoplasmic side, they associate with the three catenins, alpha, beta, and gamma (plakoglobin). This association links the cadherin protein to the cytoskeleton. Without association with the catenins, the cadherins are non-adhesive. Cadherins play a role in development, specifically in tissue formation. They may also help to maintain tissue architecture in the adult. E‑Cadherin may also play a role in tumor development, as loss of E‑Cadherin has been associated with tumor invasiveness. E‑Cadherin is a classical cadherin molecule. Classical cadherins consist of a large extracellular domain which contains DXD and DXNDN repeats responsible for mediating calcium‑dependent adhesion, a single-pass transmembrane domain, and a short carboxy-terminal cytoplasmic domain responsible for interacting with the catenins. E‑Cadherin contains five extracellular calcium‑binding domains of approximately 110 amino acids each.
References
- Bussemakers, M.J.G. et al. (1993) Mol. Biol. Reports 17:123.
- Overduin, M. et al. (1995) Science 267:386.
- Takeichi, M. (1991) Science 251:1451.
Alternate Names
Gene Symbol
UniProt
Additional E-Cadherin Products
Product Documents for Human/Mouse E-Cadherin Antibody
Product Specific Notices for Human/Mouse E-Cadherin Antibody
For research use only